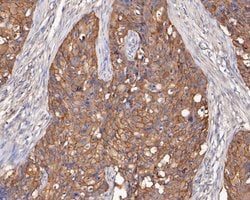
Invitrogen EGFR Monoclonal Antibody (7-F2-F8) 100 &mu;L; Unconjugated:Antibodies,

Learn More
Invitrogen™ EGFR Monoclonal Antibody (7-F2-F8)


Description
Positive Control: A431 cell lysate, SKOV-3 cell lysate, A549 cell lysate, A549, MC3T3, human breast carcinoma tissue, human placenta tissue, A431. Subcellular Location: Golgi apparatus membrane, nucleus membrane, nucleus, cell membrane, endosome, endosome membrane, endoplasmic reticulum membrane.

Specifications
Specifications
| Antigen | EGFR |
| Applications | Flow Cytometry, Immunohistochemistry (Paraffin), Western Blot, Western Blot |
| Classification | Monoclonal |
| Clone | 7-F2-F8 |
| Concentration | 2 mg/mL |
| Conjugate | Unconjugated |
| Formulation | PBS with 0.2% BSA, 50% glycerol and 0.05% sodium azide; pH 7.4 |
| Gene | EGFR |
| Gene Accession No. | P00533 |
| Gene Alias | 2.7.10.1; 9030024J15Rik; AI552599; avian erythroblastic leukemia viral (v-erbB) oncogene homolog; avian erythroblastic leukemia viral (v-erb-b) oncogene homolog; cell growth inhibiting protein 40; cell proliferation-inducing protein 61; EC 2.7.10.1; egf receptor; Egfr; EGFR-related peptide; epidermal growth factor receptor; epidermal growth factor receptor (erythroblastic leukemia viral (v-erb-b) oncogene homolog, avian); Epidermal growth factor receptor formerly avian erythroblastic leukemia viral (v-erbB) oncogene homolog (Erbb1); epidermal growth factor receptor, formerly avian erythroblastic leukemia viral (v-erbB) oncogene homolog (Erbb1); ERBB; ERBB1; ErbB-1; erb-b2 receptor tyrosine kinase 1; Errb1; Errp; HER1; kinase EGFR; mENA; NISBD2; Oncogene ERBB; PIG61; Proto-oncogene c-ErbB-1; receptor tyrosine-protein kinase erbB-1; Urogastrone; wa2; wa-2; Wa5; waved 2 |
| Show More |
By clicking Submit, you acknowledge that you may be contacted by Fisher Scientific in regards to the feedback you have provided in this form. We will not share your information for any other purposes. All contact information provided shall also be maintained in accordance with our Privacy Policy.